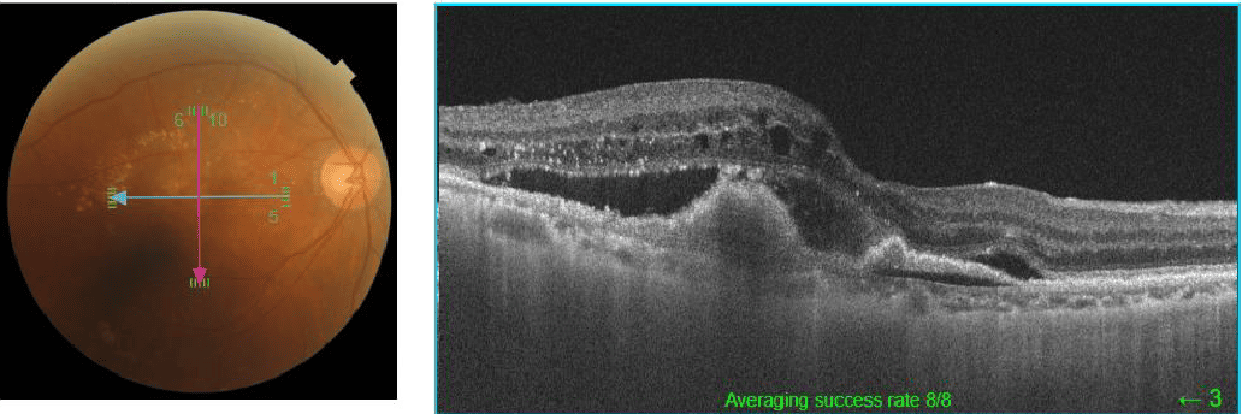
image
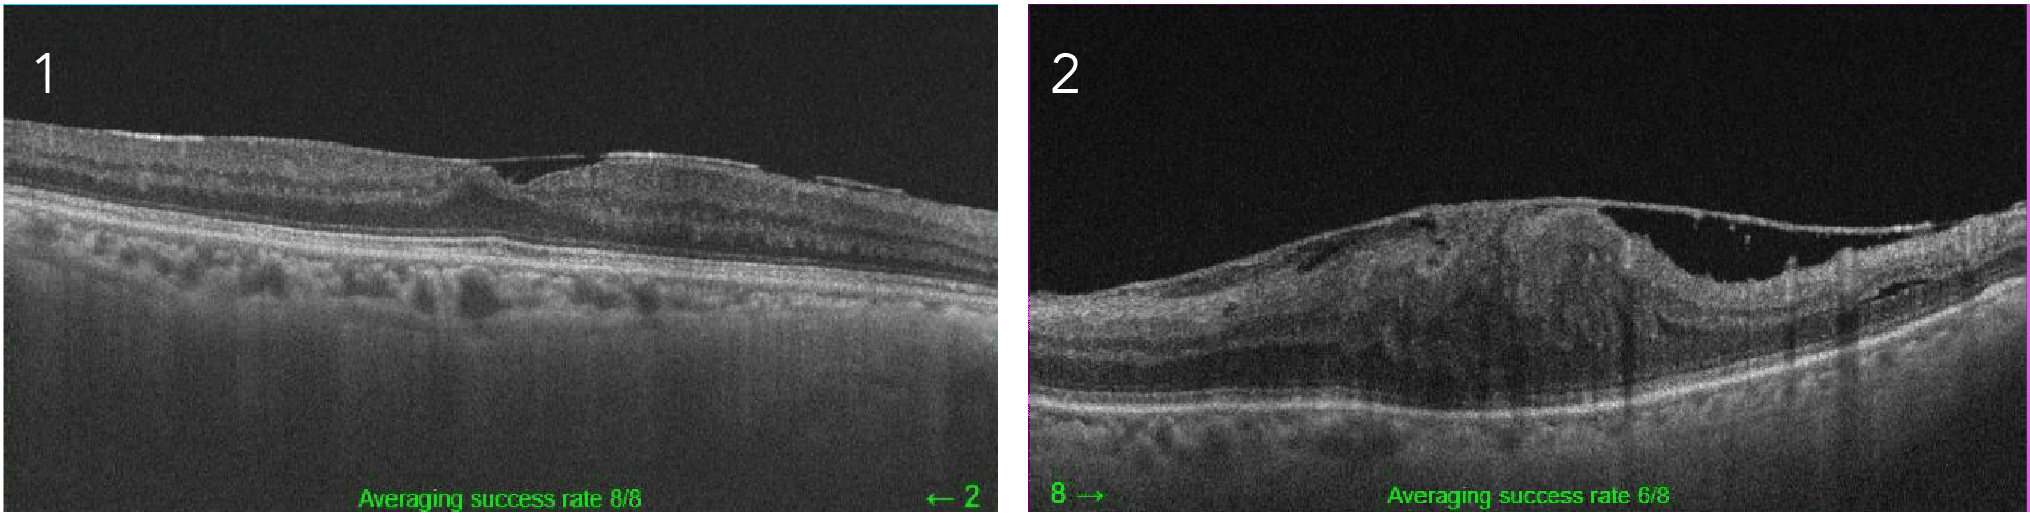
網膜上膜 (黄斑前膜)

加齢黄斑変性
加齢によって黄斑部に出血、白斑やドルーゼン(浮腫・老廃物のかたまり)がでたり、滲出液といわれる血管から染み出た液が網膜に溜まるため、網膜剥離などを引き起こします。
日本人はこの滲出型(ウェット型)が多く早期に症状が現れ、進行すると失明につながります。


治療は、抗VGEF硝子体注射や、網膜にレーザーを当てる(網膜光凝固)などがあります。
- 原因
- 加齢(50歳以上)、喫煙
- 食生活(カロチン・ビタミン不足)、遺伝
- 症状
- ものが歪んで見える
- 視力が下がる
- 中心部分が見えづらい
網膜剥離 (飛蚊症)
網膜とは目の奥にある神経の集まった膜で、見たものを写すカメラのフィルムのような役割をする部分です。この網膜が剥がれることを網膜剥離といいます。
剥がれる際に、目に痛みなどは感じないので早期発見が難しい病気です。
治療が遅れると、最悪の場合失明してしまうため以下の症状を感じたら早めに眼科受診をしてください。
- 網膜剥離の症状
-
飛蚊症
(小さな虫や糸くず)が以前より多く見えるようになった、または急激に増えた。
- 片目ずつで見たときに見えない部分や暗い部分がある。
-
光視症
光がないところで光を感じる。
- 物が歪んで見えたり小さく見える。
- 急激な視力低下を感じる。
 網膜剥離の症例写真
網膜剥離の症例写真

後部硝子体剥離
後部硝子体剝離は、飛蚊症や光視症といった網膜剥離と似た症状が現れます。
目の中には、眼球の形を保つためにゲル状の内容物があり、それを硝子体といいます。加齢とともに、硝子体ゲルが壊れて液化すると硝子体の中に液化部分ができます。
この液化した部分が小さな影のように見えるため、飛蚊症が現れます。
加齢が進み、液化が進むとゲル状の硝子体部分が縮み網膜との接合部が剥がれます。
網膜は刺激により光を感じるため、剥がれる時の刺激で光視症が現れるのです。後部硝子剥離は加齢に伴う生理的な現象のため、心配はいりません。
ただ網膜剥離と症状が似ているため、飛蚊症や・光視症があった時は眼科受診をおすすめします。
網膜色素変性
網膜色素変性は、網膜の中にある視細胞が障害されて、光を感知できなくなったり暗所での視力低下や、徐々に視野が狭くなってしまう、先天性の遺伝疾患です。
20~40歳頃に発症し、暗い場所や夜間に視力低下を感じます。
進行は緩やかで、急激に見えなくなる病気ではありませんが、最終的には失明につながる病気です。
眼科では進行を遅らせるための治療や、視野が狭くなった時の生活のアドバイス・進行した症状の方への視覚障害者手帳申請検査などを行います。
- 網膜色素変性の症状
- 暗い場所は見えにくい、暗がりで目が慣れるのに時間がかかる。
- 晴れていても夜空の星が見えにくい。
- つまづく、物や人にぶつかることがある。

- 眼底所見
- 網膜全体の色調不良
- 30°部分にリング状に骨小体状の色素沈着
- 網膜血管の狭細化
- 初期の眼底では、わずかに色むらがみられる程度
黄斑円孔
加齢によって硝子体が縮み網膜から剥離する時に、硝子体と網膜中心窩がぴったりくっついているとくっついた網膜を縮んだ硝子体が引っ張ってしまい、網膜に穴があいてしまうことが原因で起こります。

- ①ステージ1(初期)
- 自覚症状がないことが多い
- 視力低下は少しだけ
- ②ステージ2(中期)
- 自覚できるほどの視力低下あり
- ものが歪んで見える
- ③ステージ3(完成期)
- 強く視力低下を感じる
- 視界の中央が凹んで見える
円孔が出来てしまった状態が長く続くと、ステージ4となり症状の改善は難しくなります。
治療方法は基本的に硝子体手術となります。
中心性漿液性脈絡網膜症
黄斑部の滲出液が溜まってなる網膜剥離のことをいいます。(血管から染み出た液で黄斑の網膜が分離する)

症状が軽度であれば特に治療を必要とせず、生活習慣の改善などによって数カ月後に自然治癒することが多いです。
喫煙や過度なアルコール摂取の軽減、ストレスの軽減、睡眠の改善などが推奨されます。しかし症状が悪化した場合には、レーザー治療や内服を行います。
- 原因
- ストレス、喫煙、過度なアルコール摂取
- 睡眠不足、妊娠、薬による副作用
- 症状
- 視力低下(軽度)
- 視界やものが凹んだり歪んで見える
- 片目ずつ見たときにものの大きさが違う
網膜上膜 (黄斑前膜)
加齢で硝子体が縮み、網膜と硝子体が剥がれる時に、硝子体の膜が網膜に残ってしまうことが原因でなります。
残った膜が増殖してしまい、網膜の表面に新しい膜を形成したものを網膜上膜や前膜といいます。ほとんどの原因は加齢ですが、その他の原因としては糖尿病、網膜剥離、ぶどう膜炎などがあります。

進行はゆっくりなため基本は経過観察ですが、生活に支障があれば手術をします。
- 症状
- 視力低下
- ものが歪んで見える
- 膜が張ったように見える